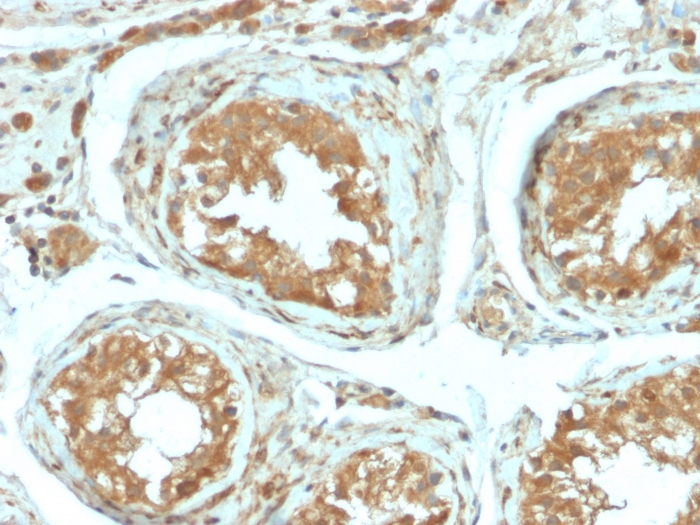
B7-H4 antibody [B7H4/2652R]

相关产品推荐更多 >
万千商家帮你免费找货
0 人在求购买到急需产品
- 详细信息
- 文献和实验
- 技术资料
- 免疫原:
A recombinant fragment of human B7-H4 protein
- 亚型:
IgG
- 形态:
Liquid
- 保存条件:
Store as concentrated solution. Centrifuge briefly prior to opening vial. Store at 4ºC.
- 克隆性:
Monoclonal
- 标记物:
Unconjugated
- 适应物种:
Human
- 保质期:
12 months from the shipping date of the product.
- 抗原来源:
Human
- 目录编号:
GTX02741
- 级别:
Primary Antibodies
- 库存:
Available
- 供应商:
GeneTex
- 宿主:
Rabbit
- 应用范围:
ICC/IF, IHC-P, FACS, ELISA
- 浓度:
200 μg/ml (Please refer to the vial label for the specific concentration.)
- 靶点:
B7-H4
- 抗体英文名:
B7-H4 antibody [B7H4/2652R]
- 抗体名:
B7-H4 抗体 [B7H4/2652R]
- 规格:
100 μg
IHC-P analysis of human testicular carcinoma section using GTX02741 B7-H4 antibody [B7H4/2652R].
FACS analysis of SKBR-3 cells using GTX02741 B7-H4 antibody [B7H4/2652R].
Blue : Primary antibody
Red : Isotype control
ICC/IF analysis of SKBR-3 cells using GTX02741 B7-H4 antibody [B7H4/2652R].
Green : Primary antibody
Red : nuclear counterstain
风险提示:丁香通仅作为第三方平台,为商家信息发布提供平台空间。用户咨询产品时请注意保护个人信息及财产安全,合理判断,谨慎选购商品,商家和用户对交易行为负责。对于医疗器械类产品,请先查证核实企业经营资质和医疗器械产品注册证情况。
文献和实验人B7-H4 ( B7-H4 )ELISA 试剂盒 ( 用于血清、血浆、细胞培养上清液和尿液生物体液内 ) 原理 本实验采用双抗体夹心 ABC-ELISA 法。用抗人 B7-H4 单抗包被于酶标板上,标准品和样品中的 B7-H4与单抗结合,加入生物素化的抗人 B7-H4 ,形成免疫复合物连接在板上,辣根过氧化物酶标记的 Streptavidin 与生物素结合,加入底物工作液显蓝色,最后加终止
Phage‐Based Expression Cloning to Identify Interacting Proteins
, W., Sellers, W.R., DeCaprio, J.A., Ajchenbaum, F., Fuchs, C.S., Chittenden, T., Li, Y., Farnham, P.J., Blanar, M.A., Livingston, D.M., and Flemington, E.K. 1992. Expression cloning of a cDNA encoding a retinoblastoma‐binding protein with E2F
a subset of genomic DNA sequences of type 5'-(NNN )3 -3', whereas the 6ZF library would recognize a subset of genomic sequences of type 5'-(NNN )6 -3'. Given the zinc-finger domains used, both libraries were more likely to recognize (RNN)x -type sequences
技术资料暂无技术资料 索取技术资料

![Insulin antibody [2D11]](https://img1.dxycdn.com/2022/0329/643/1560503088754020453-14.jpg!wh200)





